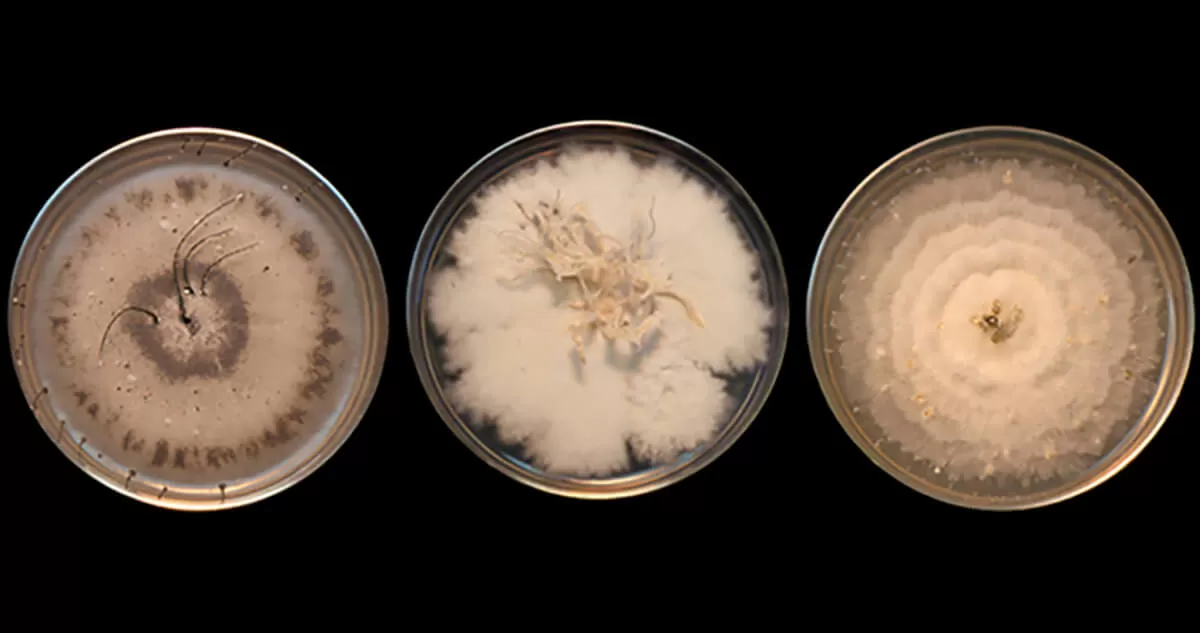
pfizer_get_science_petri_hero_image.jpg

Using Big Data to Discover Nature’s Medicine
Computer programmers and data scientists are working with microbiologists and chemists to unlock the medicinal potential of natural products.
For thousands of years, medicine has turned to nature for inspiration and potential cures. The bark of the yew tree, the slimy sea hare and even fungus have helped lead scientists to medicines for fighting cancer, high cholesterol and other conditions. As recent as last year, the natural products field took the spotlight when a Nobel Prize in Physiology or Medicine was awarded to Satoshi Omura, a Japanese microbiologist, and William C. Campbell, a parasite biology expert in the U.S., for discovering a new therapy derived from soil bacteria that can treat River Blindness and other parasitic diseases.
But successes aside, discovering effective compounds from natural products has been a very time- and labor-intensive process – until now. By combining cutting-edge gene sequencing and mass spectrometry with big data technology, scientists are poised to take a process that has largely relied on trial and error and potentially put it into hyperdrive.

Close-up image of bacterial strains from the Pfizer collection. (Courtesy Jeffrey Janso)
Using Technology to Take Advantage of Eons of Evolution
Over millions of years, nature has selected for compounds that provide adaptive advantages and could be useful medicines. “You’re letting evolution do chemistry for you,” said Edmund Graziani, a research fellow and head of natural products at Pfizer’s Groton, Connecticut site. “Now we can begin this really powerful process where we take advantage of eons of evolution – what these microbes will do in terms of their chemistry. And harness that through modern technology and computing tools to rapidly identify things that could be really important for human health.”
In the past seven decades, Pfizer has assembled hundreds of thousands of microbe samples, making it potentially one of the largest collections in the world. Freeze-dried and sealed in glass tubes, the samples have all been stored at the company’s research and development facility in Groton, CT. But because testing each one would require teams of people and potentially years to grow and test, Graziani said most of the samples have largely been untouched over the years.
Tapping Into a Treasure Trove of Biodiversity
“We have this huge library of biodiversity sitting in our vaults,” he said. “Now we’re going to try to figure out which bugs are the most productive using this modern technology. It will revolutionize how we get the best drugs from nature.”
Historically, he said, studying a microbe has involved growing it through a fermentation process not unlike brewing beer. Then scientists must extract out the different compounds and test each one to figure out what they can do. But often, even after years of work, he said, scientists may find that that they’ve just re-discovered something already known or that a potentially interesting compound lacks the chemical properties necessary for a new medicine.

Microbe library at Pfizer Groton. (Courtesy Jeffrey Janso)
No More ‘Chasing Phantoms’
But thanks to cutting-edge analytical tools, scientists can skip these labor-intensive processes. “The beauty of this new approach is that you don’t have to grow anything, you don’t have to extract anything and you’re not chasing phantom activity,” Graziani said. “You’re using the power of genome sequencing, big data algorithms and other technology to predict the compounds right up front and make educated guesses about what you think they will do.”
Using technology, scientists can scan a microbe’s entire genome, generating a blue print, and then strategically and surgically grow and test the compounds with the most potential. Working with a multi-disciplinary team of computer programmers, microbiologists, chemists and data scientists, Graziani said, the hope is to identify new compounds to test.
“There’s huge potential locked up in these organisms,” he said. “We’re just getting started but technology has evolved to this perfect point where we believe we can really build an engine of discovery that finds the most compelling molecules from nature.”




